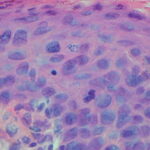

Erythroplasia of Queyrat =التنسج الأحمر لكيرات
ERYTHROPLASIA OF QUEYRAT
Etiology and Pathogenesis
Erythroplasia of Queyrat (EQ) is an in situ SCC affecting the mucosal surfaces of the penis in uncircumcised males. This condition was described by Queyrat in 1911 as “erythroplasie du gland.” The term erythroplasia of Queyrat, rather than simply SCC in situ or BD, is preferred for this condition because it is clinically distinct, presenting as a well-demarcated, shiny, velvety, bright red plaque. EQ occurs in uncircumcised men between the ages of 20 and 80 years, although the majority of cases are seen between the third and sixth decades. Risk factors for the development of this condition in uncircumcised males include poor hygiene, accumulation of smegma, heat, friction, trauma, and genital herpes simplex virus infection. Co-infection with HPV sub-types 8 and 16 was identified in almost all EQ lesions that were investigated in one study. Additional co-infection with HPV sub-types 39 and/or 51 was seen in several of these lesions. This study proposed that EQ differs from BD and other genital neoplasias in that co-infection with HPV-8 and other carcinogenic genital HPV types occurs in EQ.
Clinical Findings
EQ presents as a glistening, red, velvety plaque on the glans penis, the prepuce, or the urethra . It begins as a solitary plaque in approximately 50 percent of cases, and as multiple plaques in the remainder. Affected males complain of localized pain, pruritus, difficulty retracting the foreskin over the glans, bleeding, and crusting .
Histopathology
Histopathologically, EQ is similar to BD as previously described. In addition, there may also be epidermal hypoplasia and many more plasma cells in the dermal infiltrate, as is often seen in other processes affecting mucosal surfaces.
Diagnosis and Differential Diagnosis
The differential diagnosis includes other benign inflammatory conditions such as psoriasis, seborrheic dermatitis, lichen planus, lichen sclerosus, candidiasis, plasma cell balanitis (Zoon balanitis), lymphogranuloma venereum, granuloma inguinale, syphilis, and drug eruptions. If the diagnosis of EQ is under consideration, a biopsy should be performed.
Prognosis and Clinical Course
Lesions of EQ persist and enlarge slowly, and they typically have been present for several years (an average of 3.4 years in one study) before a biopsy is taken. Progression of EQ to invasive SCC is more common than for the lesions of BD and is said to occur in approximately 10 percent of cases. Once invasive SCC has occurred, approximately 20 percent of patients will display evidence of regional lymph node involvement or more distant metastases.
Treatment and Prevention
Prevention of EQ in uncircumcised males may be maximized by adherence to good personal hygiene regimens, and early circumcision may also reduce the incidence of this disease. Several treatment options are available, including excision, Mohs micrographic surgery, CO2 laser ablation, topical 5-FU, and topical imiquimod. Because of the
strong association of EQ with HPV infection, topical imiquimod would intuitively seem a likely treatment choice for EQ. Several case reports have demonstrated its efficacy in treating EQ, but no large, well-designed studies have been published to date to confirm its efficacy in treating this disease. Review of current data indicates that PDT does not yet seem to be as effective as a lone treatment modality for EQ.